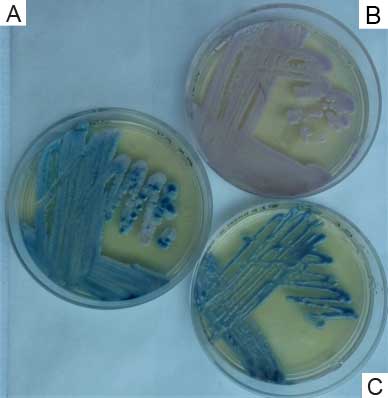

Aportación original
Recepción: 07/08/2017
Aprobación: 17/05/2019
Resumen:
Introducción: la candidiasis esofágica (CE) es la causa más común de esofagitis infecciosa. Su principal factor de riesgo ha sido la infección por VIH. En México ha sido poco estudiada.
Objetivos: determinar las características clínico-epidemiológicas de la CE e identificar sus agentes etiológicos y su sensibilidad a antifúngicos.
Métodos: se incluyeron pacientes a quienes se les detectaron placas blanquecinas durante una endoscopía esofágica, en un periodo de un año, en un hospital de tercer nivel de atención. Se tomó muestra de las placas para examen microscópico, cultivo, y estudios de sensibilidad.
Resultados: de 1763 pacientes estudiados, 23 presentaron placas blanquecinas; 13 fueron hombres; la mitad tenía de 20 a 40 años de edad; la principal comorbilidad fue cirrosis hepática; el uso de omeprazol fue significativo. Se obtuvieron 22 aislados de 17 pacientes; predominaron Candida albicans (14) y Candida parapsilosis (3). En cinco casos se encontró asociación de dos especies v. g. Candida famata con Trichosporon mucoides. La mitad de los aislados mostró resistencia a antimicóticos.
Conclusiones: la frecuencia de CE fue similar a la de otras casuísticas. Los aislados obtenidos mostraron resistencia elevada a compuestos azólicos y a caspofungina, información relevante para tomar una decisión terapéutica.
Palabras clave: Candidiasis, Esófago, Candida albicans, Antifúngicos.
Abstract:
Background: Esophageal candidiasis (EC) is the most common cause of infectious esophagitis. So far, its main risk factor has been HIV infection; in recent years, EC has been favoured by the increasing of diabetes mellitus, wide-spread use of acid-lowering agents, broad-spectrum antibiotics, and inhaled steroids. In Mexico EC has been poorly studied.
Objectives: To determine the clinical and epidemiological characteristics of EC, and to identify its etiological agents as well as its antifungal susceptibility.
Methods: Patients who revealed the presence of scattered white spots through an upper gastrointestinal system endoscopy, in a period of one year, in a tertiary care hospital, were included. Samples from patches were collected for microscopic examination, culture, and susceptibility tests.
Results: Out of 1763 patients studied, 23 had scattered white spots, and most of them presented Kodsi grade I; 13 were men; half of the patients were between the ages 20 to 40; main comorbidity was liver cirrhosis; use of omeprazole was significant. 22 isolates were obtained from 17 patients. The most frequent species were C. albicans (14) and C. parapsilosis (3). In five cases we found a two-species association v. g. Candida famata with Trichosporon mucoides. Half of the isolates showed resistance to one or several antifungal drugs.
Conclusions: EC frequency in this study was similar to other studies’ results. Obtained isolates showed high resistance to azolic compounds and to caspofungin, which is relevant information to take a therapeutic decision.
Keywords: Candidiasis, Esophagus, Candida albicans, Antifungal Agents.
Mundialmente la candidiasis es la micosis oportunista más frecuente. Dependiendo de los factores predisponentes, las formas clínicas pueden ser superficiales y de tratamiento fácil; o bien, ser infecciones profundas, invasivas, que pueden llegar a causar la muerte.1,2
La primera descripción de esta infección fue hecha hace más de 2000 años por Hipócrates, quien hizo referencia a la infección bucal en un paciente con tuberculosis pulmonar; posteriormente, se describieron otras localizaciones, aunque durante siglos, la candidiasis esofágica (CE) fue prácticamente desconocida;3 empezó a tener relevancia epidemiológica a partir de la década de los años 50 del siglo pasado, por la utilización extensa de antibióticos de amplio espectro por tiempo prolongado y el uso de antiinflamatorios esteroideos de alta potencia. Tres décadas después, con el advenimiento del síndrome de inmunodeficiencia adquirida (SIDA) y la observación de que más de 50% de los enfermos de SIDA presentaban candidiasis, esta infección motivó numerosas investigaciones,4,5 así se estableció su relación con el número de linfocitos CD4 (anteriormente conocidos de manera general como linfocitos t cooperadores).6
El género Candida está integrado aproximadamente por 200 especies, algunas forman parte de la biota normal de piel o mucosas. Muchas de las especies de este género no pueden desarrollarse en los tejidos humanos y por ese motivo sólo alrededor de 20 son reportadas con frecuencia como agentes etiológicos de candidiasis. Las principales especies registradas son Candida albicans, Candida parapsilosis, Candida tropicalis, Candida glabrata, Candida guilliermondii, Candida krusei, Candida kefyr, Candida lusitaniae, Candida dubliniensis, Candida famatay Candida ciferri.7,8
Para que se desarrolle una infección por Candida spp. en cualquier localización, es necesario que el paciente presente factores predisponentes, mismos que pueden ser locales y temporales, como aumento de humedad, maceración, cambio de pH; o permanentes, como edad avanzada, diabetes mellitus, cáncer, enfermedades autoinmunes, insuficiencia renal, insuficiencia hepática; otras situaciones que la facilitan son desnutrición, intervención quirúrgica, administración prolongada de antibióticos de amplio espectro, administración de antiinflamatorios esteroideos, hospitalización prolongada (mayor riesgo en pacientes de cuidados intensivos), y cualquier otra condición que ocasione inmunosupresión general.9, 10
El esófago está cubierto por una mucosa que por sus características normales de humedad puede ser el hábitat de algunas especies de Candida, aunque en escasa cantidad;11 también es una vía de paso de alimentos, mismos que pueden contener levaduras de Candida en cantidad variable, algunas de las cuales podrían adherirse y causar colonización o infección. Los factores de riesgo que con mayor frecuencia han sido reportados en los casos de CE son infección por el virus de inmunodeficiencia humana (VIH), enfermedad de Sjögren, hipoparatiroidismo, insuficiencia suprarrenal, administración de antagonistas de los receptores H2, inhibidores de la bomba de protones, broncodilatadores administrados en aerosol.12 Algunos pacientes presentan trastornos motores esofágicos, como, por ejemplo, esclerosis sistémica13 y acalasia. Entre los factores generales que favorecen la CE se encuentran la desnutrición y la edad avanzada asociada al uso de prótesis bucales con mala higiene. La CE ha sido considerada como un marcador de patologías graves como la infección por VIH o cáncer.14,15,16
La mayoría de los pacientes con CE son asintomáticos; algunos pacientes presentan odinofagia y dolor retroesternal leve o moderado. En la práctica clínica la diferenciación entre colonización e infección se basa en la presencia de lesiones eritematosas cubiertas de una pseudomembrana blanquecina. Estas lesiones se clasifican de acuerdo con la escala de Kodsi en cuatro grados: I, placas elevadas hasta 2 mm, escasas, grises o blanquecinas, con hiperemia, sin edema ni ulceración; II, múltiples placas elevadas, mayores de 2 mm, con hiperemia y edema, sin ulceraciones; III, placas confluentes, lineales y nodulares, con hiperemia y úlceras; IV, lo descrito para el grado III y, además, friabilidad de la mucosa y, ocasionalmente, estrechez de la luz esofágica. En los casos de colonización, las placas están ausentes.17
Al estudiar un paciente con candidiasis, es importante identificar las especies causantes, ya que además de contribuir al conocimiento epidemiológico de la enfermedad para elegir el tratamiento adecuado, debe considerarse que la especie aislada puede presentar características especiales. Por ejemplo, todos los aislados de C. krusei son intrínsecamente resistentes al fluconazol;18 la C. dubliniensis aislada de pacientes con VIH desarrolla rápidamente resistencia frente a algunos compuestos azólicos.19
En el Hospital de Especialidades “Dr. Bernardo Sepúlveda” del Instituto Mexicano del Seguro Social (IMSS), se atiende a un gran número de pacientes que presentan uno o varios de los factores predisponentes para desarrollar CE; sin embargo, debido a que en la gran mayoría de los casos la infección no ocasiona síntomas, no se ha realizado un estudio para detectar esta micosis de manera dirigida. Los objetivos de esta investigación fueron determinar la frecuencia de CE en los pacientes del hospital sometidos a endoscopía; conocer características clínico-epidemiológicas de los pacientes; relacionar la CE con otras patologías o tratamientos; determinar la frecuencia de cada una de las especies levaduriformes, y establecer su perfil de sensibilidad a antifúngicos.
Material y métodos
Se realizó un estudio transversal, descriptivo y prospectivo, con la autorización del Comité Local de Investigación y Ética en Investigación en Salud 3601 del IMSS (R-2015-3601-167).
Durante un periodo de 12 meses fueron incluidos todos los pacientes ambulatorios, adultos, hombres y mujeres, quienes tenían cita en el hospital de estudio para practicarles un estudio de endoscopía esofágica, por cualquier causa.
Se registró el motivo de solicitud del estudio endoscópico y se buscó intencionadamente la presencia de placas blanquecinas sugestivas de CE. Al observar estas lesiones, se procedió a hacer un cepillado y la muestra fue colocada en un tubo con solución salina isotónica estéril y transportada al Laboratorio de Micología Médica para su estudio: examen microscópico con hidróxido de potasio al 15% (KOH), frotis con tinción de Gram y cultivo en agar dextrosa Sabouraud (ADS) con y sin antibióticos (cicloheximida y cloranfenicol). A partir de los cultivos con desarrollo se procedió a su identificación por estudios morfológicos (cultivo en agar harina de maíz) y fisiológicos (filamentación en suero; cultivo en CHROMagar Candida®20 y en agar tabaco,21 y auxanograma automatizado en equipo Vitek 2 Biomerieux®.
Para confirmar la identidad de los diferentes aislados se llevó a cabo un estudio molecular, partiendo de la extracción de ácido desoxirribonucleico (ADN) mediante el Exgene Plant SV mini kit (GeneAll, Biotechnology, Corea), con el cumplimiento de sus instrucciones. Para todos los aislados se realizó una reacción en cadena de polimerasa (por sus siglas en inglés PCR) punto final, para la ampliación de la región ITS, con los iniciadores ITS1 (5’-TCC GTA GGT GAA CCT GCG G-3’) e ITS4 (5’-TCC TCC GCT TAT TGA TAT GC-3’). Las condiciones de esta reacción se basaron en el reporte de Mohammadi et al. Con este procedimiento, el tamaño del amplicón es diferente dependiendo de la especie (entre 510 y 881 pb); todos los amplicones obtenidos fueron digeridos con la enzima de restricción Mspl.22 De acuerdo con el tamaño del producto de digestión se determinó la especie. Para diferenciar las especies C. albicans y C. dubliniensis se realizó una PCR dúplex dirigida a las regiones ITS1 e ITS2, con los iniciadores CALF (5’-TGG TAA GGC GGG ATC GCT T 3’), CALR (5’-GGT CAA AGT TTG AAG ATA TAC 3’), CDUF (5’-AAA CTT GTC ACG AGA TTA TTT TT 3’) y CDUR (5’-AAA GTT TGA AGA ATA AAA TGG C 3’), según las condiciones de Ahmad et al.23 Para conformar la identidad del complejo de C. parapsilosis, se hizo una segunda PCR para amplificar el gen SADH y posteriormente se procedió a digerir el amplicón (720 pb) con la enzima BanI. De acuerdo con los fragmentos de restricción, se determinó la identidad de los componentes de este complejo.24 La especie de T mucoides fue identificada por PCR-secuenciación; la secuencia fue comparada en la base de datos del Genbank (https://www.ncbi.nlm.nih.gov/genbank/).
A todos los aislados se les determinó su sensibilidad a itraconazol, fluconazol, voriconazol, posaconazol, anfotericina B y caspofungina, por la técnica de microdilución en caldo, siguiendo la metodología y guías propuestas por el Clinical and Laboratory Standards Institute de Estados Unidos de América en su documento M27-A3.25
De los pacientes con cultivos positivos a levaduras, se registraron los datos de edad y sexo, comorbilidades y factores predisponentes como diabetes mellitus, infección por VIH, cáncer, trastornos motores esofágicos y administración de esteroides, inmunosupresores, antibióticos de amplio espectro, antiácidos, antimicóticos, broncodilatadores y esteroides en aerosol. Los síntomas considerados fueron disfagia, dolor retroesternal, odinofagia y fiebre.
La clasificación de la CE al llevar a cabo la endoscopía se realizó de acuerdo con la antes mencionada escala de Kodsi.17
En el análisis estadístico se utilizaron las pruebas chi cuadrada y exacta de Fisher para las variables nominales, así como la prueba t de Student para variables cuantitativas. Se analizó la asociación entre comorbilidades, síntomas, exposición a fármacos, edad y sexo, con la presencia de CE y su grado de afección observado endoscópicamente (programa de IBM SPSS Statistics Editor, versión 22 para Windows®).
Resultados
Durante los 12 meses de estudio se realizaron 1763 endoscopías; en 23 pacientes se observaron placas blanquecinas, clínicamente compatibles con CE (1.13%); 13 pacientes fueron hombres. El rango de edad fue de 22 a 83 años con una media de 56.5. Los grupos de edad predominantes fueron de 20 a 40 (50%) y de 41 a 60 años (24%).
Las comorbilidades más frecuentes en los 23 pacientes fueron: cirrosis hepática (siete), hipertensión arterial (cinco), diabetes mellitus (cuatro) e insuficiencia renal (tres). En cuatro pacientes no se refirió patología alguna.
En los 23 pacientes que presentaban placas blanquecinas, los motivos de envío para estudio endoscópico fueron diversos (cuadro I). Las patologías predominantes fueron estenosis esofágica (21.7%), disfagia (17.4%), esófago de Barrett (13.0% y várices esofágicas (13.0%).
Diagnóstico de envío para solicitar el estudio de endoscopía esofágica

De los 23 pacientes estudiados, en cinco (21.7%) no se documentó el uso de algún fármaco. Los 18 pacientes restantes (78.2%) consumían algún fármaco en el momento de la endoscopía: seis (26.08% del total de 23) utilizaban antimicóticos o antibacterianos (trimetoprim/sulfametoxazol, amoxicilina, fluconazol, eritromicina, ceftriaxona o tigeciclina); 17 pacientes (73.91%) reportaron el uso de inhibidores de la bomba de protones; cinco (21.73%) tomaban inmunosupresores; tres utilizaban prednisona y además, dos de ellos micofenolato y azatioprina; el uso de antihistamínicos H2 fue referido por dos pacientes (8.69%). La única asociación estadísticamente significativa entre CE y el uso de algún fármaco se presentó con el uso de inhibidores de la bomba de protones (omeprazol), con un valor de p = 0.019. El uso de prótesis dentarias se documentó en nueve casos (39.13%), sin significación estadística.
De acuerdo con la clasificación de Kodsi, 14 pacientes tuvieron lesiones de grado I, siete de grado II y dos de grado III. En ninguno de los casos se observaron lesiones compatibles con el grado IV (figura 1)

Figura 1
Imágenes de endoscopía esofágica de tres pacientes con candidiasis
De izquierda a derecha, Kodsi I, II y III. El número de placas blanquecinas se incrementa de acuerdo con el grado de afección. En la imagen de la derecha son evidentes las lesiones eritematosas y ulcerosas.
En los 23 pacientes que presentaron placas blanquecinas, el examen microscópico (examen directo con KOH 15% y frotis con tinción de Gram) mostró la presencia de estructuras fúngicas (levaduras, pseudohifas e hifas). El cultivo en ADS, con y sin antibióticos, fue positivo en 17 pacientes (74%). Con base en el cultivo en el medio cromógeno, en cinco casos se detectó más de una especie, por lo que el número final fueron 22 aislados (figura 2).
Figura 2
A) Aislamiento primario en medio de CHROMAgar donde se observan dos tonalidades, una verde intensa y otra blanquecina, lo que indica una infección mixta.
B) Candida famata aislada del cultivo primario
C) Aislamiento purificado de Trichosporon mucoides a partir del aislado inicial.
El medio de agar tabaco mostró su utilidad para inducir la formación de clamidoconidios en C. albicans. Ninguno de los aislados mostró la distribución de estas estructuras compatibles con C. dubliniensis (filogenéticamente cercana a C. albicans).
El auxanograma automatizado permitió la identificación confiable de todas las especies de Candida, excepto C. guilliermondii (dos casos) y el complejo C. parapsilosis (tres casos).
Los géneros y las especies identificadas, así como el resultado del estudio de sensibilidad antifúngica son mostrados en el cuadro II. Las especies identificadas con mayor frecuencia fueron C. albicans (14), seguida de C. parapsilosis (tres). En cinco pacientes se aisló más de una especie; las asociaciones observadas fueron C. albicans y C. glabrata (dos casos); C. albicans y C. lusitaniae (un caso); C. albicans y C. kefyr (un caso),y C. famata y Trichosporon mucoides (un caso).
Sensibilidad a antifúngicos en las especies identificadas

ITZ itraconazol; FLZ fluconazol; VRZ voriconazol; PSZ posaconazol; AMB anfotericina B; CSF caspofungina; *Con resistencia a antifúngicos
El estudio de sensibilidad mostró que 11 de los 22 aislados (50%) presentaban resistencia a uno o varios de los antimicóticos empleados habitualmente para el tratamiento (cuadro III).
Número total de aislados resistentes a seis antifúngicos de uso frecuente

ITZ itraconazol; FLZ fluconazol; VRZ voriconazol; PSZ posaconazol; AMB anfotericina B; CSF caspofungina
De los 21 aislados de Candida spp., 10 (47.61 %) mostraron resistencia a uno o varios antimicóticos, entre los que predominó C. albicans (23.5%); tres de ellos fueron resistentes a todos los compuestos azólicos probados. El único aislado de C. famata fue resistente a anfotericina B y el T. mucoides a caspofungina; ambos fueron obtenidos del mismo paciente.
Discusión
Los resultados de la presente investigación hacen notar que en los pacientes del hospital de estudio la frecuencia de CE fue de 1.3%. Esta es semejante a la reportada en otras investigaciones de países como Argentina (2.57 %)26 y Japón (1.17 %).27 En pacientes con VIH la frecuencia sin duda se incrementa, como fue reportado en una cohorte de 80 219 pacientes estudiados entre 2002 y 2014, en la que se observó CE en 9.8% de los pacientes infectados por VIH frente a 1.6% de pacientes sin esta infección.28 En la población estudiada ninguno de los pacientes tenía infección por VIH, lo cual podría explicar el número reducido de pacientes con CE.
En relación con la edad y el sexo de los pacientes con CE, las observaciones fueron similares a las casuísticas de otros países: hubo una frecuencia semejante entre hombres y mujeres, con predominio en la sexta década de vida.26,27 En México no existen reportes de prevalencia de CE en grupos específicos de pacientes y en general en el mundo; las publicaciones relacionadas con la candidiasis hacen referencia principalmente a casos clínicos sintomáticos de comportamiento inusual.29,30
La gravedad de las lesiones esofágicas grado IV de la clasificación de Kodsi no fue identificada como ha sido reportado en otro estudio, principalmente en pacientes con SIDA, con un bajo número de CD4,31 condición que no se presentó en el grupo de pacientes de este estudio, probablemente por la vigilancia adecuada de los pacientes con SIDA del hospital.
De los 23 pacientes con placas blanquecinas y con examen microscópico positivo, en seis no se obtuvieron cultivos. Una posible explicación es que los pacientes con frecuencia toman antimicóticos, aun sin prescripción médica. Por otro lado, Bisawas et al. reportaron que el lansoprazol, inhibidor de la bomba de protones, es capaz de inhibir el crecimiento hifal in vitro de Candida albicans.32 Esta interacción explicaría los cultivos negativos, pero no la baja frecuencia de CE en los pacientes. En cinco de los 17 pacientes con cultivos positivos, se aislaron dos agentes diferentes; esto es importante, dado que en ocasiones la respuesta terapéutica es inadecuada ante infecciones mixtas, pues presentan susceptibilidad diferente a un antimicótico.33
De las ocho especies identificadas, C. albicans, C. guilliermondii y C. glabrata mostraron resistencia a uno o varios antimicóticos azólicos. En reportes mundiales, estas tres especies se encuentran entre las más patógenas cuando causan infecciones sistémicas, por lo que tener un foco infeccioso con alguno de estos agentes es un factor de riesgo para cualquier paciente.34
Los aislados fúngicos de Candida spp. mostraron mayor resistencia a itraconazol, 9 de 22 (40.9%). Esto probablemente se debe al uso habitual de este compuesto en población abierta, aun sin diagnóstico preciso de micosis y a dosis inadecuadas. Es frecuente que al laboratorio se presenten pacientes con diversas dermatosis, quienes refieren que toman “100 mg de itraconazol”, por un lapso entre 4 y 6 meses, sin haberse realizado estudios micológicos. Los dos aislados de C. guilliermondii y el de T. mucoides fueron resistentes a caspofungina, lo que demuestra la necesidad de hacer estudios de sensibilidad en todos los casos de candidiasis profundas; de otra manera, se estará ejerciendo una presión selectiva sobre múltiples agentes, como ha ocurrido con otros antifúngicos.35
Un dato alarmante obtenido en este trabajo es el incremento del porcentaje de aislados resistentes en pacientes del hospital. En un trabajo reportado en 2008, el porcentaje de especies de Candida resistentes a compuestos azólicos fue de 27.5%;36 en el estudio actual, 47.61% de los aislados mostraron resistencia a varios de los compuestos; seis de estos (28.57%) fueron resistentes a posaconazol, uno de los últimos azólicos incluidos en la terapéutica antifúngica. De no ponerse atención a este problema, sin duda se incrementará el número de casos de falla terapéutica.
Con relación al T. mucoides, se ha reportado un caso de infección sistémica causada por este agente;37 generalmente es causante de infecciones superficiales y rara vez se le ha encontrado en onicomicosis.38 Hasta el momento, no hay reportes de infección esofágica por T. mucoides, pero sí por T. beigelii y T. inkin.39,40 Por lo tanto, el significado epidemiológico de este aislamiento en la esofagitis por T. mucoides se establecerá conforme se publiquen nuevas revisiones y aunque la clasificación de este agente por estudios morfológicos y bioquímicos puede prestarse a duda, las técnicas moleculares empleadas para determinar la taxonomía precisa del aislado deben ser de sensibilidad y especificidad altas.
Es necesario hacer el estudio en otros centros médicos para determinar la prevalencia de esta patología y las asociaciones que presenta en pacientes mexicanos. Aumentar el número de aislados fúngicos disminuiría sesgos asociados a la baja frecuencia de algunos de los agentes como T. mucoides, C. kefyr, C. famata y C. lusitaniae.
Conclusiones
La CE en el hospital de estudio es una patología con frecuencia de 1.13%. De acuerdo con la severidad, la mayoría de los pacientes se clasifican como Kodsi I. Las lesiones llegan a tener una etiología mixta, incluso con agentes no reportados previamente. Aunque los pacientes incluidos en este estudio recibían diversos tratamientos, solo hubo una asociación estadísticamente significativa con el omeprazol. En los aislados micóticos se observó un alto índice de resistencia antifúngica a itraconazol, que es el compuesto triazólico con mayor antigüedad de uso; también se identificó resistencia a compuestos recientes de síntesis, como el posaconazol y la caspofungina, por lo que a todos los aislados de CE debería realizárseles estudio de sensibilidad antes de prescribir el tratamiento.
Agradecimientos
A Jamie Zabicky López y Cecilia Neri Badillo, por el apoyo en la realización de algunos ensayos moleculares y pruebas fisiológicas de identificación.
Referencias
1. Quindós G, Aguirre-Urizar JM, Ribacoba-Bajo L, Olaechea-Astigarraba P, Erasio-Barrio E, Zaragoza-Crespo R. Candidiasis. En: Micología Clínica. Quindós G (Ed.) España: Elsevier; 2015. pp. 87-107.
2. Pfaller MA, Diekema DJ. Epidemiology of invasive candidiasis: a persistent public health problem. Clin Microbiol Rev. 2007; 20 (1): 133-63.
3. Drouhet E. Historical introduction: evolution of knowledge of the fungi and mycoses from Hippocrates to the twenty-first century. En: Topley and Wilson’s Microbiology and Microbial Infections: Medical Mycology. Merz WG, Hay RJ. (Eds.). London: Hodder Arnold; 2005. pp. 3-42.
4. Odds FC, Schmid J, Soll DR. Epidemiology of Candida infections in AIDS. En: Bossche HV, Mackenzie DWR, Cauwenbergh G, Van Cutsem J, Drouhet E, Dupont B (Eds). Mycoses in AIDS Patients. Boston: Springer;1990.pp.67-74. DOI: 10.1007/978-1-4613-0655-9_5
5. Kaur R, Dhakad MS, Goyal R, Bhalla P, Dewan R. Spectrum of Opportunistic Fungal Infections in HIV/AIDS Patients in Tertiary Care Hospital in India. Can J Infect Dis Med Microbiol.2016;2016:2373424. DOI: 10.1155/2016/2373424
6. Warnock DW. Immunological aspects of candidosis in AIDS patients. En: Bossche HV, Mackenzie DWR, Cauwenbergh G, Van Cutsem J. Mycoses in AIDS Patients. Boston: Springer; 1990. pp. 83-91. DOI: 10.1007/978-1-4613-0655-9_7
7. Segal E, Elad D. Candidiasis. En: Topley and Wilson’s Microbiology and Microbial Infections: Medical Mycology. Merz WG, Hay RJ (Eds.) London: Hodder Arnold; 2005. pp. 579-623.
8. Trofa D, Gácser A, Nosanchuk JD. Candida parapsilosis, an Emerging Fungal Pathogen. Clin Microbiol Rev. 2008;21(4):606-25. DOI: https://doi.org/10.1128/CMR.00013-08
9. Yang Y, Guo F, Kang Y, Zang B, Cui W, Qin B, et al. Epidemiology, clinical characteristics, and risk factors for mortality of early- and late-onset invasive candidiasis in intensive care units in China. Medicine (Baltimore). 2017; 96(42):e7830. DOI: 10.1097/MD.0000000000007830
10. Cornistein W, Mora A, Orellana N, Capparelli FJ, del Castillo M. Candida: epidemiología y factores de riesgo para especies no albicans. Enferm Infecc Microbiol Clin. 2013;31(6):380-4.
11. Kennedy MJ. Regulation of Candida albicans Populations in the Gastrointestinal tract: Mechanisms and Significance in GI and Systemic Candidiasis. En: McGinnis MR, Borgers (Edits.) Current Topics in Medical Micology, vol. 3. New York: Springer; 1989. pp. 315-402.
12. Palacios-Martínez D, Díaz-Alonso RA, Gutiérrez-López M, Gordillo-López FJ, Arranz-Martínez E, Ruiz-García A. Esofagitis candidiásica en una paciente inmunocompetente: a propósito de un caso. An Sist Sanit Navar. 2013;36(3):551-6.
13. Marie I, Ducrotte P, Denis P, Hellot MF, Levesque H. Oesophageal mucosal involvement in patients with systemic sclerosis receiving proton pump inhibitor therapy. Aliment Pharmacol Ther. 2006;24(11-12):1593-601. DOI: https://doi.org/10.1111/j.1365-2036.2006.03180.x
14. Choi JH, Lee CG, Lim YJ, Kang HW, Lim CY, Choi JS. Prevalence and risk factors of esophageal candidiasis in healthy individuals: A single center experience in Korea. Yonsei Med J. 2013;54(1):160-5. DOI: https://doi.org/10.3349/ymj.2013.54.1.160
15. Flores de Apodaca-Verdura Z, Martínez-Machín G, Ruiz-Pérez A, Fernández-Andreu CM, Muné-Jiménez L, Perurena-Lancha M. Candidiasis esofágica en pacientes con sida. Estudio clínico y microbiológico. Rev Cubana Med Trop. 1998;50(2):110-4.
16. Alsomali MI, Arnold MA, Frankel WL, Graham RP, Hart PA, Lam-Himlin DM, et al. Challenges to "Classic" Esophageal Candidiasis: Looks Are Usually Deceiving. Am J Clin Pathol. 2017;147(1):33-42. DOI: 10.1093/ajcp/aqw210
17. Kodsi BE, Wickremesinghe C, Kozinn PJ, Iswara K, Goldberg PK. Candida esophagitis: a prospective study of 27 cases. Gastroenterology. 1976;71(5):715-9.
18. Rex JH, Pfaller MA, Galgiani JN, Bartlett MS, Espinel-Ingroff A, Ghannoum MA, et al. Development of Interpretive Breakpoints for Antifungal Susceptibility Testing: Conceptual Framework and Analysis of In Vitro-In Vivo Correlation Data for Fluconazole, Itraconazole, and Candida Infections. Clin Infect Dis. 1997;24(2):235-47. DOI: 10.1093/clinids/24.2.235
19. Bosch E, López-Gobernado M, Valentín A, Calabuig EC, Viudes A, Velázquez-Cantón E, et. al. Actividad in vitro del voriconazol frente a levaduras y algas con los nuevos puntos de corte del patrón de resistencia. Rev Esp Quimioter. 2006;19(1):21-33.
20. Hospenthal DR, Beckius ML, Floyd KL, Horvath LL, Murray CK. Presumptive identification of Candida species other than C. albicans, C. krusei, and C. tropicalis with the chromogenic medium CHROMagar Candida. Ann Clin Microbiol Antimicrob. 2006;5:1-5. DOI: 10.1186/1476-0711-5-1
21. Khan ZU, Ahmad S, Mokaddas E, Chandy R. Tobacco agar, a new medium for differentiating Candida dubliniensis from Candida albicans. J Clin Microbiol. 2004;42(10):4796-8. DOI: 10.1128/JCM.42.10.4796-4798.2004
22. Mohammadi R, Mirhendi H, Rezaei-Matehkolaei A, Ghahri M, Shidfar MR, Jalalizand N, et al. Molecular identification and distribution profile of Candida species isolated from Iranian patients. Med Mycol. 2013;51(6):657-63. DOI: 10.3109/13693786.2013.770603
23. Ahmad S, Khan Z, Asadzadeh M, Theyyathel A, Chandy R. Performance comparison of phenotypic and molecular methods for detection and differentiation of Candida albicans and Candida dubliniensis. BMC Infect Dis. 2012;12:230. DOI: 10.1186/1471-2334-12-230
24. Tavanti A, Davidson AD, Gow NA, Maiden MC, Odds FC. Candida orthopsilosis and Candida metapsilosis spp. nov. to replace Candida parapsilosis groups II and III. J Clin Microbiol. 2005;43(1):284-92. DOI: 10.1128/JCM.43.1.284-292.2005
25. Clinical and Laboratory Standards Institute. Reference Method for Broth Dilution Antifungal Susceptibility Testing of Yeasts; Approved Standard-Third Edition. M27-A3, 2008 Vol. 28, No. 14. Disponible en https://clsi.org/media/1461/m27a3_sample.pdf
26. Olmos MA, Araya V, Concetti H, Ramallo J, Piskorz E, Pérez H et al. Candidiasis esofágica: análisis clínico y micológico. Acta Gastroenterol Latinoam. 2005;35(4):211-8.
27. Naito Y, Yoshikawa T, Oyamada H, Tainaka K, Morita Y, Kogawa T, et al. Esophageal candidiasis. Gastroenterol Jpn. 1988;23(4):363-70.
28. Takahashi Y, Nagata N, Shimbo T, Nishijima T, Watanabe K, Aoki T, et al. Long-Term Trends in Esophageal Candidiasis Prevalence and Associated Risk Factors with or without HIV Infection: Lessons from an Endoscopic Study of 80,219 Patients. PLOS ONE. 2015;10(7): e0133589. DOI:10.1371/journal.pone.0133589
29. Aghdam MR, Sund S. Invasive Esophageal Candidiasis with Chronic Mediastinal Abscess and Fatal Pneumomediastinum. Am J Case Rep. 2016; 17: 466-71. DOI: https://dx.doi.org/10.12659%2FAJCR.898053
30. Casaubon-Garcin PR, Vázquez-Orihuela H, Sada-Díaz E, Ortiz-Hidalgo C. Esofagitis por Candida secundaria a uso de clindamicina tópica. Informe de un caso. Anales Médicos. 2012;57(3):252-5.
31. Asayama N, Nagata N, Shimbo T, Nishimura S, Igari T, Akiyama J, et al. Relationship between clinical factors and severity of esophageal candidiasis according to Kodsi’s classification. Dis Esophagus. 2014;27(3):214-9. DOI: 10.1111/dote.12102
32. Bisawas SK, Yokoyama K, Kamei K, Nishimura K, Miyaji M. Inhibition of hyphal growth of Candida albicans by activated lansoprazole, a novel benzimidazole proton pump inhibitor. Med Mycol. 2001;39(3):283-5. DOI: 10.1080/mmy.39.3.283.285
33. Lindberg E, Hammarström H, Ataollahy N, Kondori N. Species distribution and antifungal drug susceptibilities of yeasts isolated from the blood samples of patients with candidemia. Sci Rep. 2019; 9(1):3838. DOI: 10.1038/s41598-019-40280-8
34. Pfaller MA, Andes DR, Diekema DJ, Horn DL, Reboli AC, Rotstein C, et al. Epidemiology and Outcomes of Invasive Candidiasis Due to Non-albicans Species of Candida in 2,496 Patients: Data from the Prospective Antifungal Therapy (PATH) Registry 2004-2008. PLoS One. 2014;9(7):e101510. DOI: https://dx.doi.org/10.1371%2Fjournal.pone.0101510
35. Anderson JB. Evolution of antifungal drug resistance: mechanisms and pathogen fitness. Nat Rev Microbiol. 2005;3(7):547-56. DOI: 10.1038/nrmicro1179
36. Manzano-Gayosso P, Méndez-Tovar LJ, Hernández-Hernández F, López-Martínez R. La resistencia a los antifúngicos: un problema emergente en México. Gac Med Mex. 2008;144(1):23-6.
37. Padhi S, Dash M, Pattanaik S, Sahu S. Fungemia due to Trichosporon mucoides in a diabetes mellitus patient: A rare case report. Indian J Med Microbiol. 2014;32(1):72-4. DOI: 10.4103/0255-0857.124324
38. Sageerabanoo, Malini A, Oudeacoumar P, Udayashankar C. Onychomycosis due to Trichosporon mucoides. Indian J Dermatol Venereol Leprol. 2011; 77(1):76-7. DOI: 10.4103/0378-6323.75001
39. Bottari M, D’Amore F, Buda CA, Magnano A, Melita G, Dell’Utri P, et al. Stenosing esophagitis caused by Trichosporon beigelii: presentation a rare case. G Chir. 1997; 18(6-7):344-7.
40. Macêdo DP, de Oliveira NT, da Silva VK, de Almeida Farias AM, de Lima Neto RG, Wilheim AB, et al. Trichosporon inkin Esophagitis: An Uncommon Disease in a Patient with Pulmonary Cancer. Mycopathologia. 2011; 171(4):279-83. DOI: 10.1007/s11046-010-9367-5
Información adicional
Declaración de conflicto de interés: los autores han completado y enviado la forma traducida al español de la declaración de conflictos potenciales de interés del Comité Internacional de Editores de Revistas Médicas, y no fue reportado alguno que tuviera relación con este artículo.
Cómo citar este artículo: Méndez-Tovar LJ, Rodríguez-Sánchez JF, Manzano-Gayosso P, Hernández-Hernández F, Blancas-Valencia JM, Silva-González I. Candidiasis esofágica en pacientes de un hospital de especialidades. Rev Med Inst Mex Seguro Soc. 2019;57(2):74-81.
PubMed: https://www.ncbi.nlm.nih.gov/pubmed/?term=31618561
Enlace alternativo
http://revistamedica.imss.gob.mx/editorial/index.php/revista_medica/article/view/1698/3617 (pdf)
http://revistamedica.imss.gob.mx/editorial/index.php/revista_medica/article/view/1698/3639 (html)
